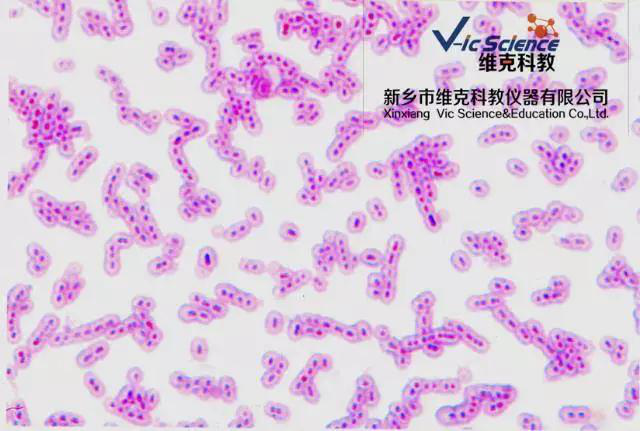
維克科教 維克科教

hotline
0373-5128357微生物切片,能幫助人們更好地進行學科研究,以觀察細胞、組織的生理、病理形態變化。微生物包括細菌、病毒、真菌以及一些小型的原生生物、顯微藻類等在內的一大類生物群體,它個體微小,與人類關系密切。涵蓋了有益跟有害的眾多種類,廣涉及食品、醫藥、工農業、環保等諸多領域。下面我們就來認識幾種常見的微生物。
霍亂弧菌
霍亂弧菌包括兩個生物型:古典生物型(Classical biotype)和埃爾托生物型(EL-Tor bio-type)。這兩種型別除個別生物學性狀稍有不同外,形態和免疫學性基本相同,在臨床病理及流行病學特征上沒有本質的差別。自1817年以來,全球共發生了七次世界性大流行,前六次病原是古典型霍亂弧菌,第七次病原是埃爾托型所致
新從病人分離出古典型霍亂弧菌和EL tor弧菌比較典型,為革蘭氏陰性菌,菌體彎曲呈弧狀或逗點狀,菌體一端有單根鞭毛和菌毛,無莢膜與芽胞。經人工培養后,易失去弧形而呈桿狀。取霍亂病人米泔水樣糞便作活菌懸滴觀察,可見細菌運動極為活潑,呈流星穿梭運動。營養要求不高,在PH8.8~9.0的堿性蛋白胨水或平板中生長良好。因其他細菌在這一PH不易生長,故堿性蛋白胨水可作為選擇性增殖霍亂弧菌的培養基。在堿性平板上菌落直徑為2mm,圓形,光滑,透明
?
炭疽桿菌
炭疽桿菌(Bacillus anthraci)屬于需氧芽胞桿菌屬,能引起羊、牛、馬等動物及人類的炭疽病。炭疽桿菌曾被帝國主義作為致死戰劑之一。平時,牧民、農民、皮毛和屠宰工作者易受感染。皮膚炭疽在我國各地還有散在發生,不就放松警惕。
炭疽桿菌菌體粗大,兩端平截或凹陷。排列似竹節狀,無鞭毛,無動力,革蘭氏染色陽性,本菌在氧氣充足,溫度適宜(25~30℃)的條件下易形成芽胞。在活體或未經解剖的尸體內,則不能形成芽胞。芽胞呈橢圓形,位于菌體中央,其寬度小于菌體的寬度。在人和動物體內能形成莢膜,在含血清和碳酸氫鈉的培養基中,孵育于CO2環境下,也能形成莢膜。形成莢膜是毒性特征。
炭疽桿菌受低濃度青霉素作用,菌體可腫大形成園珠,稱為“串珠反應”。這也是炭疽桿菌特有的反應

肉毒芽胞桿菌
在一定條件下,炭疽桿菌能在菌體內形成一個折光性很強的不易著色小體,稱為內芽胞(Endospore),簡稱芽胞
芽胞一般只在動物體外才能形成,并受環境影響,當營養缺乏,特別是碳源、氮源或磷酸鹽缺乏時,容易形成芽胞。不同細菌開成芽胞還需不同的條件,如炭疽桿菌須在有氧條件下才能形成芽胞。成熟的芽胞可被許多正常代謝物如丙氨酸、腺苷、葡萄糖、乳酸等激活而發芽,先是芽胞酶活化,皮質層及外殼迅速解聚,水分進入,在合適的營養和溫度條件下,芽胞的核心向外生長成繁殖體,開始發育和分裂繁殖。芽胞并非細菌的繁殖體,而是處于代謝相對靜止的休眠休態,以維持細菌生存的持久體。
大腸桿菌
大腸細菌(E. coli)為埃希氏菌屬(Escherichia)代表菌。一般多不致病,為人和動物腸道中的常居菌,在一定條件下可引起腸道外感染。某些血清型菌株的致病性強,引起腹瀉,統稱病致病大腸桿菌
大小0.4~0.7×1~3um,無芽胞,大多數菌株有動力。有普通菌毛與性菌毛,有些菌株有多糖類包膜,革蘭氏陰性桿菌
在血瓊脂平板上,有些菌株產生β型溶血。在鑒別性或選擇性培養基上形成有顏色、直徑2~3mm的光滑型菌落。
生化反應:大部分菌株發酵乳糖產酸產氣,并發酵葡萄糖、麥芽胞、甘露醇、木膠糖、阿拉伯膠等產酸產氣。IMViC試驗為“+、+、-、-”。即為典型大腸桿菌
?
支原體菌落
支原體有時被稱為類菌質體。無細胞壁,多呈不規則球狀、長絲狀,可分枝,營寄生共生或腐生。一般侵害對象為動植物,可造成多種疾病。
支原體(Mycoplasmal)是目前所能發現的能在無生命培基中生長繁殖的最小的微生物。
支原體體形多樣,基本為球形,亦可呈球桿狀或絲狀,其菌落呈針尖大小,故又稱之為微小支原體。支原體特點是無細胞壁及前體,細胞器極少。DNA的G+C含量低,菌體內具有非常小的染色體組,其分子量約為45×108,菌體細胞大小約為0.2-0.3μm,很少超過1.0μm。由三層蛋白質和脂質組成的膜樣結構以及一層類似毛發結構組成。支原體由二分裂繁殖,形態多樣。支原體用普通染色法不易著色,用姬姆薩染色很淺,革蘭氏染色為陰性。支原體可在雞胚絨毛尿囊膜上或細胞培養中生長。用培養基培養。營養要求比細菌高。由于它沒有細胞壁,因此對影響細胞壁合成的抗生素,如青霉素等不敏感,但紅霉素、四環素、卡那霉素、鏈霉素、氯霉素等作用于核蛋白體的抗生素,可抑制或影響支原體的蛋白質合成,有殺傷支原體作用,支原體對熱抵抗力差,通常55℃經15分鐘處理可使之滅活。石碳酸,來蘇兒易將其殺死。在培養基中置入脲素并以硫酸錳作指示劑極易與其他支原體作出鑒別。
?
肺炎鏈球菌莢膜
肺炎鏈球菌仍然是嚴重侵襲性感染(如腦膜炎、膿毒癥、肺炎)和上呼吸道感染重要的病原體之一
肺炎鏈球菌(gtreptococcuspneumonias),舊稱肺炎雙球菌或肺炎球菌(pneumococci),為革蘭氏陽性雙球菌,屬鏈球菌的一種。肺炎鏈球菌根據其莢膜特異性多糖抗原分型,目前丹麥分84型(丹麥血清研究所為被WHO認可的唯一抗血清來源),美國分86個血清型。我國曾在80年代進行全國范圍致病菌型調查,從血、腦脊液和中耳分泌物分離的菌株以5型多,其次為6、1、19、23、14、2、3、型等。肺炎鏈球菌可引起大葉肺炎,皆為原發性,大多數見于3歲以上小兒,年長兒較多。因此時機體防御能力逐漸成熟,能使病變局限于一個肺葉或一個節段而不致擴散。嬰幼兒時期偶可發生。氣候驟變時機體抵抗力降低,發病較多,冬春季多見,可能與呼吸道病毒感染流行有一定關系
破傷風芽胞桿菌
破傷風桿菌,它常以孢子的形式存在于家畜的糞便和土壤中。在含氧量少的地方,可以存活許多年。如果孩子碰著從土中挖出的釘子等物而受傷時,其孢子就會進入人體,在深部組織進行繁殖。
?
幽門螺桿菌?
1983年,澳大利亞兩位科學家,從慢性胃炎的胃粘膜中取樣,在微需氧的條件下,培養出幽門螺桿菌(Hp)
一般認為幽門螺桿菌僅寄居于人類,人是唯一的傳染源。幽門螺桿菌多系口-口傳染,因為在牙菌斑中可以培養出幽門螺桿菌。而糞-口傳染途徑尚未得到證實。
許多固體培養基能用作分離培養Hp的基礎培養基。例如:心腦浸液瓊脂、哥倫比亞瓊脂、布氏瓊脂和M-H瓊脂等。但必需加入適量的全血(馬、羊或人)或胎牛血清作為補充物。加入適量的活性炭(0.2%)或淀粉(1%)亦有利于吸收培養基中衍化產生的毒性氧離子。Hp生長緩慢,通常需要3d~5d,甚至更長時間,才能形成針尖狀小菌落,為了避免快速生長的兼性厭O2菌和霉菌等和過度生長,常需加入由萬古霉素、TMP、兩性霉素、多粘菌素等組合的抑菌劑。Hp在液體培養基中生長更加困難。這可能與在液體里面更難保證菌體周圍穩定的微含O2量環境有關

綠膿桿菌單鞭毛
綠膿桿菌屬于假單胞菌屬,是一種能運動的革蘭氏陰性桿菌,大小為1.5~3.0μm×0.5~0.8μm,單在、成雙,有時呈短鏈。
本菌在普通培養基上生長良好,形成的菌落為圓形,中等大小,隆起,濕潤粘稠,多數邊緣整齊(用低倍鏡觀察邊緣薄而不齊,似葵花瓣狀?),淡綠色,菌落周圍的培養基為藍綠色,有芳香氣味;在普通肉湯中培養24h呈均勻渾濁,繼續培養至72h可產生菌膜,培養液呈藍綠色,并且呈粘糊狀,用白金鉺蘸取少許能拉成絲狀;藍綠色的綠膿菌素可溶于水。本菌在麥康凱培養基上生長良好,菌落呈灰綠色;在三糖鐵培養基上不產生硫化氫,菌落呈灰色,斜面部位呈粉紅色,底部不變黃。本菌發酵部分糖不產氣,過氧化氫酶陽性,氧化酶陽性,需氧。

變形桿菌周身鞭毛
變形桿菌(proteus species)廣存在于水、土壤***的有機物以及人和動物的腸道中,為條件致病菌,多為繼發感染,如慢性中耳炎、創傷感染等,也可引起膀胱炎、嬰兒腹瀉、食物中毒等。變形桿菌屬包括普通變形桿菌、奇異變形桿菌、莫根變形桿菌、雷極變形桿菌和無恒變形桿菌。其中以普通變形桿菌和奇異變形桿菌與臨床關系較密切。特別是奇異變形桿菌可引起敗血癥,病死率較高。
變形桿菌呈明顯的多形性,有球形和絲狀形,為周鞭毛菌,運動活潑。在固體培養基上呈擴散生長,形成遷徒生長現象。若在培養基中加入0.1%石碳酸或 0.4%硼酸可以抑制其擴散生長,形成一般的單個菌落。在ss平板上可以形成圓形、扁薄、半透明的菌落,易與其它腸道致病菌混淆。培養物有特殊臭味,在血瓊脂平板上有溶血現象。能迅速分解尿素。根據菌體抗原分群,再以鞭毛抗原分型。此屬細菌x19、xk、x2的o抗原與某些立克次體的部分抗原有交叉,可替代立克次體抗原與患者血清作凝集反應,此反應稱為外斐試驗(weil-felix test),用于某些立克次體病的輔助診斷。

? ?新鄉市維克科教儀器有限公司確保庫存生物玻片60萬張,其中組培切片、人體病理組織學切片、微生物切片、細胞生物學切片與遺傳學切片以及血液檢驗 學切片占有很大比重,是中國較大較全的生物玻片標本生產基地,我司產品不僅暢銷全國,還與多位國外友人有戰略合作,以全球化的視角定位公司產品及服務。致力于滿足生物實驗室需求,打造國際生物教育科研級品牌。更多詳情請聯系我們。